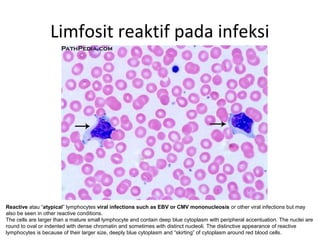
Limfosit reaktif pada infeksi
Reactive atau “atypical” lymphocytes viral infections such as EBV or CMV mononucleosis or other viral infections but may
also be seen in other reactive conditions.
The cells are larger than a mature small lymphocyte and contain deep blue cytoplasm with peripheral accentuation. The nuclei are
round to oval or indented with dense chromatin and sometimes with distinct nucleoli. The distinctive appearance of reactive
lymphocytes is because of their larger size, deeply blue cytoplasm and “skirting” of cytoplasm around red blood cells.
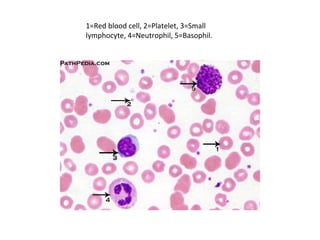
1=Red blood cell, 2=Platelet, 3=Small
lymphocyte, 4=Neutrophil, 5=Basophil.
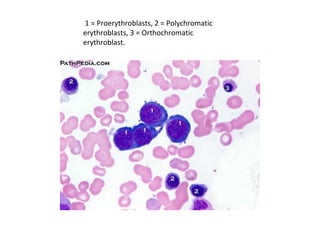
1 = Proerythroblasts, 2 = Polychromatic
erythroblasts, 3 = Orthochromatic
erythroblast.

Dokumen ini membahas prinsip pengamatan dan identifikasi sel-sel darah serta evolusi seri sel dalam sumsum tulang. Terdapat detail tentang bentuk dan karakteristik berbagai sel darah, termasuk limfosit, mieloblas, dan eritrosit, serta perbedaan antara sel-sel tersebut. Informasi juga mencakup pengamatan lain seperti ukuran, warna sitoplasma, dan rasio inti-sitoplasma untuk membedakan sel muda dan tua.